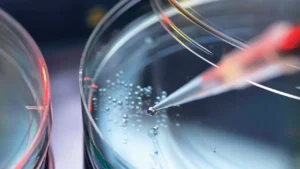
Una nueva resina ABS es capaz de eliminar la estática: te contamos cómo

Noticias de última hora
- 29 / 05 : STADLER impulsa el crecimiento a largo plazo y la sostenibilidad de FLACIPEL
- 29 / 05 : Plásticos biodegradables en suelos: Europa impulsa nuevos materiales para agricultura sostenible
- 28 / 05 : Lucifer Lighting integra plástico oceánico reciclado en luminarias arquitectónicas fabricadas por moldeo por inyección
- 28 / 05 : Claims de sostenibilidad en envases: la Generación Z exige más transparencia a las marcas
- 27 / 05 : STADLER abre nueva oficina en Japón para impulsar soluciones de clasificación y reciclaje